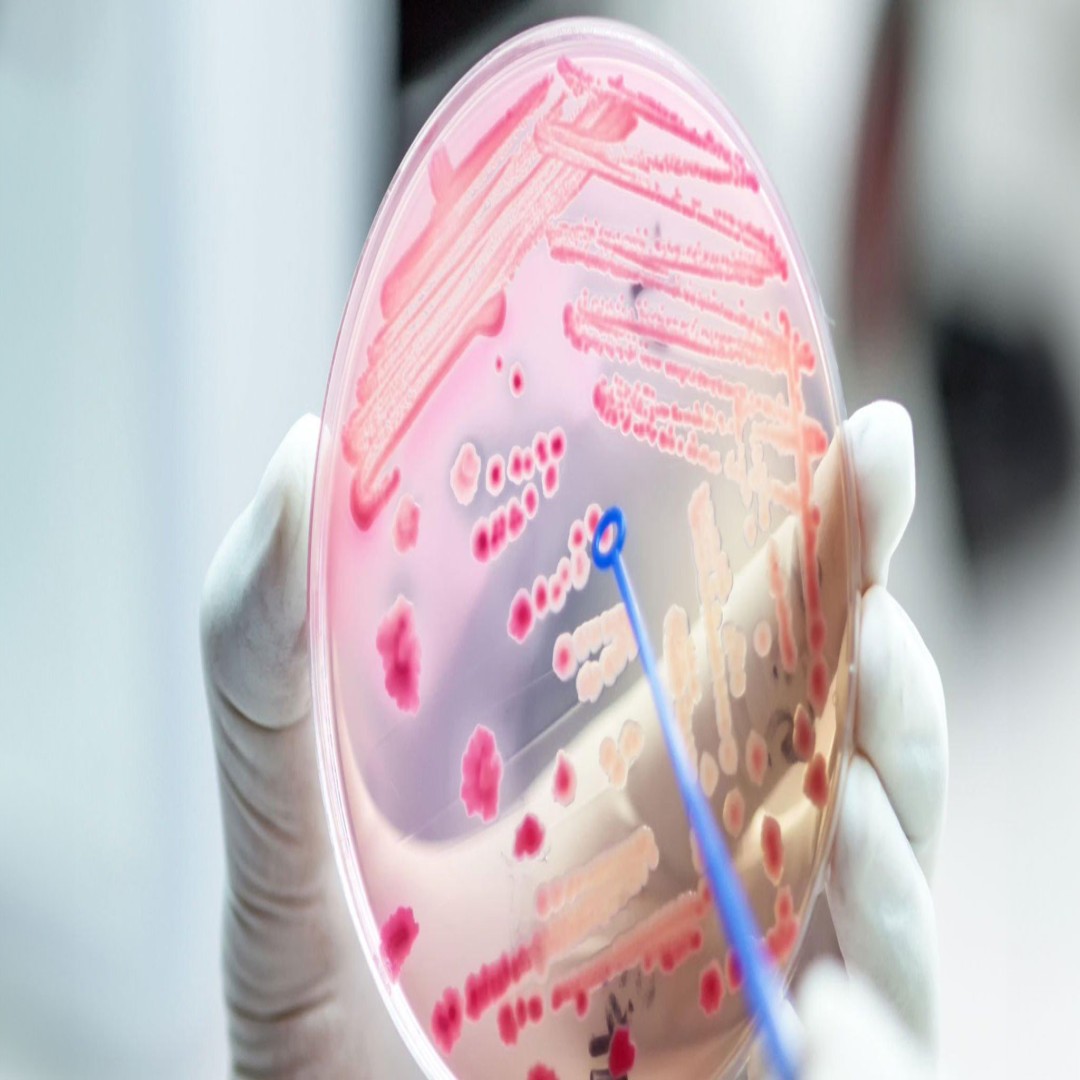
Sepsis Tanısı: Kan Dolaşımı Enfeksiyonunun Teşhisi |

Sepsis Tanısı: Kan Dolaşımı Enfeksiyonunun Teşhisi
-
- 27.11.2023
- 0
Yorum
-
Enfeksiyon Hastalıkları
Sepsis tanısının konulması için kullanılan yöntemler ve testler. Kan kültürü ve SepsiTest gibi yöntemlerin önemi ve doğru tanının tedaviye katkısı. Erken teşhis hayati önem taşır.
Sepsis (kan dolaşımı enfeksiyonu) tanısı nasıl konur?
Sepsis, kan dolaşımına bakteri, virüs, mantar gibi bir enfeksiyon etkeninin karışması sonucunda ortaya çıkar. Bu enfeksiyon etkeni kana karışarak tüm vücuda yayılır ve organlara zarar verebilir.
Sepsis, hayati tehlike arz eden bir durumdur ve ölüm oranı %40 civarındadır. Bu nedenle, erken tanı ve tedavi önemlidir.
Sepsis tanısı için aşağıdaki yöntemler kullanılabilir:
Kan Kültürü: Sepsis geçiren hastaların ateşli olduğu dönemde kan örneği alınarak bakteri veya mantar üretimi için laboratuvara gönderilir. Ancak bu yöntemin bazı dezavantajları vardır. Sonuçların alınması uzun sürebilir ve yavaş üreyen enfeksiyon etkenlerinde sonuçlar daha geç elde edilebilir. Ayrıca, hastanın antibiyotik kullanması sonucu etkileyebilir. Bu nedenle, kan kültürü pozitiflik oranı (%15-25) düşüktür.
SepsiTest (PCR Testi): Kan dolaşımı enfeksiyonuna hızlı bir şekilde tanı koymak için kullanılan moleküler bir PCR testidir. Bu test, kan örneği üzerinde çalışılarak kan dolaşımında bulunan 700'den fazla bakteri ve mantarı tespit eder. Test, bakteri ve mantarların DNA'sını saptayarak çalışır. Bu test antibiyotik kullanımından etkilenmez ve tedaviye yanıtı değerlendirmede etkili olabilir.
SepsiTest, 4 saat içinde kan örneğinde bakteri veya mantar varlığını belirler. Negatif sonuç, enfeksiyon etkeninin olmadığını gösterir ve test sonlandırılır. Pozitif sonuç durumunda test devam eder ve kan dolaşımında enfeksiyona sebep olan bakteri veya mantarın ismi belirlenir. Buna göre tedavi planlanır. SepsiTest, zaman zaman hayat kurtarıcı bir test olabilir.
Özet olarak, sepsis tanısı için kan kültürü ve SepsiTest gibi yöntemler kullanılabilir. Bu testler, doğru tanı konulmasına ve uygun tedaviye yönlendirilmesine yardımcı olabilir. Sağlıkla kalın! Eğer herhangi bir sorunuz varsa, lütfen yorumlarda paylaşın. Sitemize abone olun ve bizi takip etmeye devam edin. Görüşmek üzere
- 27.11.2023
- 0 Yorum
- Enfeksiyon Hastalıkları
Sepsis tanısının konulması için kullanılan yöntemler ve testler. Kan kültürü ve SepsiTest gibi yöntemlerin önemi ve doğru tanının tedaviye katkısı. Erken teşhis hayati önem taşır.
Sepsis (kan dolaşımı enfeksiyonu) tanısı nasıl konur?
Sepsis, kan dolaşımına bakteri, virüs, mantar gibi bir enfeksiyon etkeninin karışması sonucunda ortaya çıkar. Bu enfeksiyon etkeni kana karışarak tüm vücuda yayılır ve organlara zarar verebilir.
Sepsis, hayati tehlike arz eden bir durumdur ve ölüm oranı %40 civarındadır. Bu nedenle, erken tanı ve tedavi önemlidir.
Sepsis tanısı için aşağıdaki yöntemler kullanılabilir:
Kan Kültürü: Sepsis geçiren hastaların ateşli olduğu dönemde kan örneği alınarak bakteri veya mantar üretimi için laboratuvara gönderilir. Ancak bu yöntemin bazı dezavantajları vardır. Sonuçların alınması uzun sürebilir ve yavaş üreyen enfeksiyon etkenlerinde sonuçlar daha geç elde edilebilir. Ayrıca, hastanın antibiyotik kullanması sonucu etkileyebilir. Bu nedenle, kan kültürü pozitiflik oranı (%15-25) düşüktür.
SepsiTest (PCR Testi): Kan dolaşımı enfeksiyonuna hızlı bir şekilde tanı koymak için kullanılan moleküler bir PCR testidir. Bu test, kan örneği üzerinde çalışılarak kan dolaşımında bulunan 700'den fazla bakteri ve mantarı tespit eder. Test, bakteri ve mantarların DNA'sını saptayarak çalışır. Bu test antibiyotik kullanımından etkilenmez ve tedaviye yanıtı değerlendirmede etkili olabilir.
SepsiTest, 4 saat içinde kan örneğinde bakteri veya mantar varlığını belirler. Negatif sonuç, enfeksiyon etkeninin olmadığını gösterir ve test sonlandırılır. Pozitif sonuç durumunda test devam eder ve kan dolaşımında enfeksiyona sebep olan bakteri veya mantarın ismi belirlenir. Buna göre tedavi planlanır. SepsiTest, zaman zaman hayat kurtarıcı bir test olabilir.
Özet olarak, sepsis tanısı için kan kültürü ve SepsiTest gibi yöntemler kullanılabilir. Bu testler, doğru tanı konulmasına ve uygun tedaviye yönlendirilmesine yardımcı olabilir. Sağlıkla kalın! Eğer herhangi bir sorunuz varsa, lütfen yorumlarda paylaşın. Sitemize abone olun ve bizi takip etmeye devam edin. Görüşmek üzere

Yorum Yazın